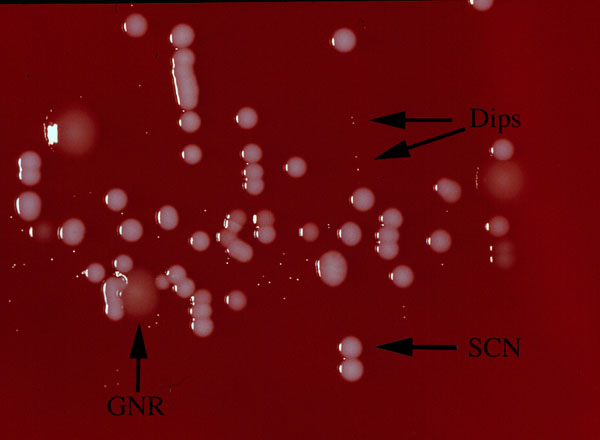

Diagnosis of urinary tract infection
Click picture to enlarge. Close window to return
For the microbiologic diagnosis of urinary tract infection, by definition, there must be >100,000 organisms/cc. This definition is used because of the common contamination of a "clean-catch" urine specimen, especially in females. The photograph to the left shows the plate from just such a specimen. It is growing colonies of at least 3 different types (arrows- Gram negative rods (GNR), diptheroids (Dips), and staph coagulase negative (SCN). This culture would be signed out as "mixed flora, probable contamination".Certain patients may have asymptomatic bacteruria, with less than 100,000 organisms/cc. Pregnant women are an example of such a patient population. Any number of organisms may be significant. In such a case, it may be worth considering straight catheterization, to obtain an optimal specimen. However, you must consider the risk that you may introduce organisms by doing a catheterization.